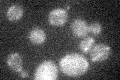
YDR260C

View description
Subunit of the anaphase-promoting complex, which is an E3 ubiquitin ligase that regulates the metaphase-anaphase transition and exit from mitosis; required for activation of the daughter-specific gene expression and spore wall maturation
Localization:
Intensity:
Fold change:
Significance:
-
C’ GFP library in SD

below threshold16.67 -
N' NOP1pr-GFP in SD

cytosol,nucleus45.9577 -
N' TEF2pr-mCherry in SD

nucleus20.1576 -
N' NATIVEpr-GFP in SD

punctate,nucleus22.8354 -
N' TEF2pr-VC and Cyto-VN in SD

below threshold25.6407 -
C’ GFP library in SD+DTT

cytosol14.420.86No -
C’ GFP library in SD+H2O2
cytosol15.520.93No -
C’ GFP library in Starvation Media

cytosol15.280.91No -
C’ GFP library on the background of Pup2-DaMP

below threshold -
C’ GFP library on the background of CCT mutant

below threshold16.89971.01364No
